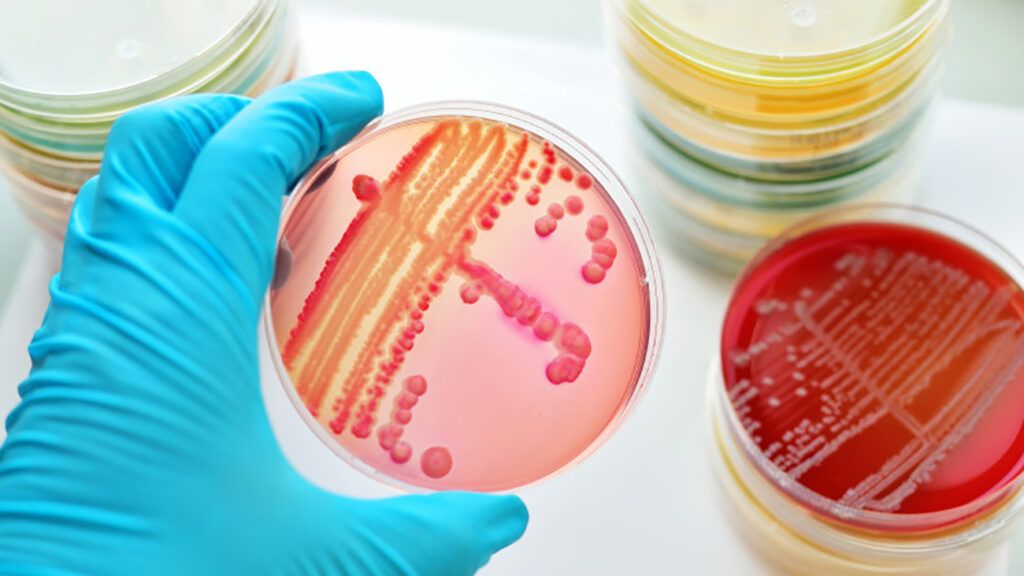

Din cuprinsul articolului
Experții avertizează că o infecție bacteriană rară, dar periculoasă, se răspândește într-un ritm alarmant în Japonia, iar autorităţile medicale se luptă să identifice cauza bolii.
Potrivit oficialilor niponi, cazuri de sindrom de șoc toxic streptococic s-au înmulţit foarte multt, având o rată de mortalitate de 30%.
Tulpini extrem de virulente
Se așteaptă ca numărul de cazuri în 2024 să depășească numărul record de anul trecut, iar îngrijorarea cea mai mare o reprezintă faptul că forma mortală a bolii streptococice de grup A – sindromul de șoc toxic streptococic (STSS) – va continua să se răspândească, după ce prezența unor tulpini extrem de virulente și infecțioase a fost confirmată deja.
“Există încă mulți factori necunoscuți în ceea ce privește mecanismele care stau la baza formelor severe și bruște de streptococ și nu suntem în stadiul în care să le putem explica”, a anunțat Institutul Național de Boli Infecțioase (NIID) din Japonia.
Cifrele provizorii publicate de NIID au înregistrat aproape 1.000 de cazuri de îmbolnăvire în 2023. În primele două luni ale acestui an, au fost deja înregistrate 378 de cazuri, infecțiile fiind identificate în toate cele 47 de prefecturi din Japonia.
În timp ce persoanele în vârstă sunt considerate mai expuse la un risc mai mare, tulpina de grup A dproduce mai multe decese în rândul pacienților sub 50 de ani. Dintre cele 65 de persoane sub 50 de ani care au fost diagnosticate cu STSS între iulie și decembrie în 2023, aproximativ o treime, adică 21, au murit, relatează presa japoneză.
30% din cazurile de STSS sunt fatale
Cele mai multe cazuri de STSS sunt cauzate de o bacterie numită streptococcus pyogenes. Cunoscută mai frecvent sub numele de streptococ A – aceasta poate provoca dureri de gât, mai ales la copii, și o mulțime de oameni o au fără să știe și nu se îmbolnăvesc.
Dar bacteria foarte contagioasă care provoacă infecția poate, în unele cazuri, să provoace boli grave și chiar deces, în special la adulții de peste 30 de ani. Potrivit experţilor niponi, aproximativ 30% din cazurile de STSS sunt fatale.
Simptome iniţiale asemănătoare răcelii la persoanele vârstnice
Persoanele în vârstă pot prezenta simptome asemănătoare răcelii, dar, în cazuri rare, simptomele se pot agrava și pot include angină streptococică, amigdalită, pneumonie și meningită. În cele mai grave cazuri, se poate ajunge la insuficiență și necrozarea organelor.
Unii experți cred că această creștere rapidă a numărului de cazuri de anul trecut a fost legată de ridicarea restricțiilor impuse în timpul pandemiei de coronavirus. Ken Kikuchi, profesor de boli infecțioase la Universitatea de Medicină a Femeilor din Tokyo, spune că este „foarte îngrijorat” de creșterea dramatică din acest an a numărului de pacienți cu infecții streptococice invazive severe.
Infecțiile streptococice, precum și cele de Covid-19, se răspândesc prin picături și contact fizic. Bacteria poate infecta pacienții și prin intermediul rănilor de pe mâini și picioare.
Infecțiile cu streptococ A sunt tratate cu antibiotice, dar pacienții cu boala streptococică invazivă mai severă vor avea probabil nevoie de o combinație de antibiotice și alte medicamente, împreună cu o atenție medicală intensivă, spun specialiștii japonezi, potrivit 360medical.ro.
Ministerul japonez al Sănătății recomandă ca populația să ia aceleași măsuri de precauție de bază în materie de igienă împotriva streptococului A care au devenit parte din viața de zi cu zi în timpul pandemiei de coronavirus.